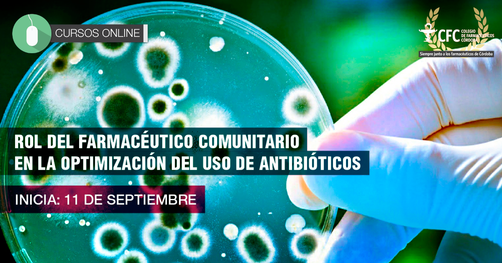

Estimados Colegas
Estimados ColegasNos estamos comunicando para invitarlos a participar de un Curso ON-LINE GRATUITO sobre el:
"ROL DEL FARMACÉUTICO COMUNITARIO EN LA OPTIMIZACIÓN DEL USO DE ANTIBIÓTICO"
Inicio: 11 de septiembre de 2020
Modalidad on-line
Este curso se encuadra dentro del proyecto de BUENAS PRÁCTICAS DE DISPENSACIÓN DE ANTIBIÓTICOS DE MAYOR DEMANDA EN LAS FARMACIAS COMUNITARIAS presentado al Foro Farmacéutico de las Américas y tiene como objetivo establecer estrategias para contribuir a la disminución de la Resistencia Antibiótica que se presenta como uno de los próximos desafíos en salud pública.
El conocimiento de las estrategias para disminuir este impacto, a la vez lograr un mejor manejo en la práctica profesional diaria a través de la dispensación de los antibióticos de mayor prevalencia, serán los temas a abordar en este curso, que estará a cargo de docentes de reconocida trayectoria.

